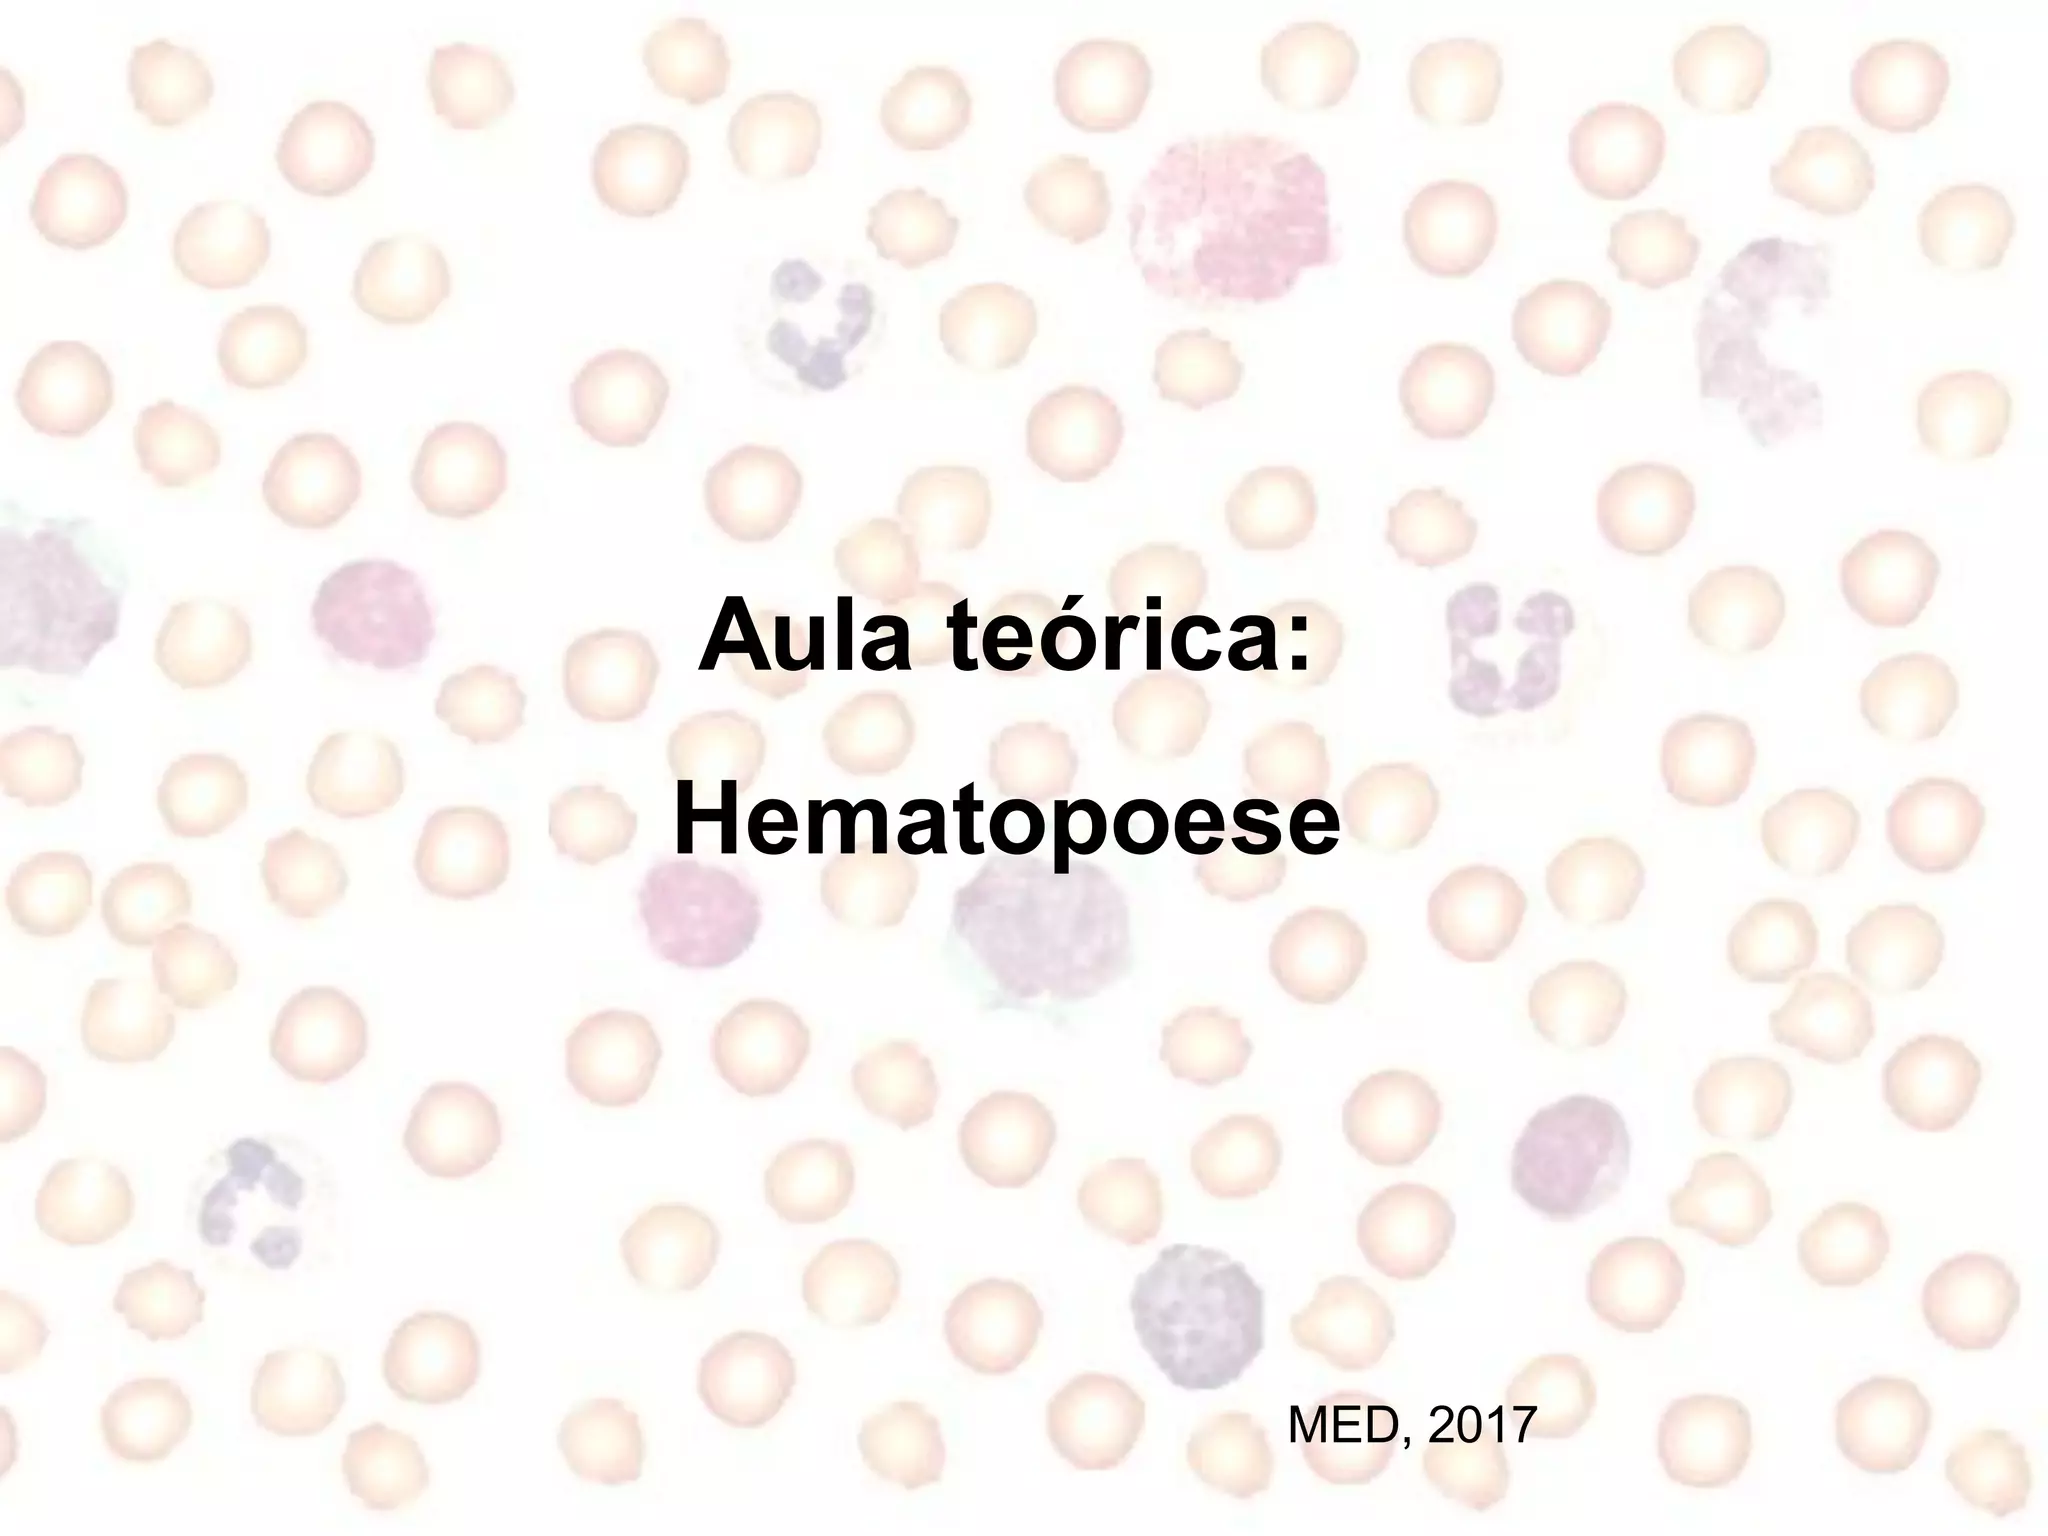
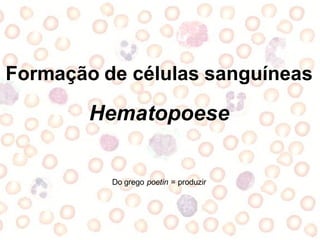
Formação de células sanguíneas
Hematopoese
Do grego poetin = produzir
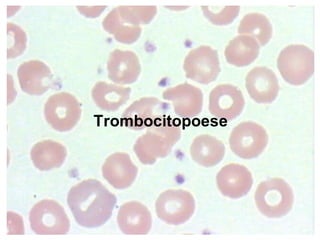
Trombocitopoese
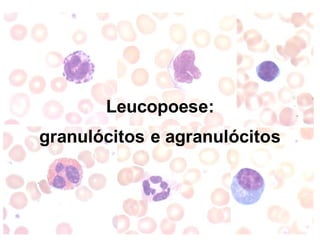
Leucopoese:
granulócitos e agranulócitos

O documento discute os processos de hematopoese e formação dos elementos figurados do sangue. Apresenta os principais locais onde ocorre a hematopoese ao longo do desenvolvimento, como a medula óssea no período pós-natal. Descreve os processos de eritropoese, trombocitopoese e leucopoese, incluindo os estágios de desenvolvimento dos eritrócitos, plaquetas, granulócitos, monócitos e linfócitos.